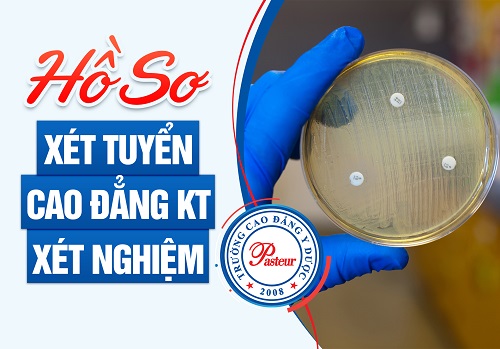
Hồ sơ tuyển sinh Cao đẳng Xét nghiệm TPHCM năm 2021 Hồ sơ tuyển sinh Cao đẳng Xét nghiệm TPHCM năm 2021

Ban tư vấn tuyển sinh Trường Cao đẳng Y dược Pasteur công bố thời gian tuyển sinh Cao đẳng Xét nghiệm TPHCM năm 2021 giúp các thí sinh có thể chủ động nộp hồ sơ về nhà trường ngay từ hôm nay.
- Mẫu hồ sơ xét tuyển Cao đẳng Xét nghiệm TPHCM mới nhất năm 2021
- Địa chỉ học Cao đẳng Xét nghiệm TPHCM uy tín năm 2021
- Chỉ tiêu tuyển sinh Cao đẳng Xét nghiệm TPHCM năm 2021 là bao nhiêu?

Ngành Xét nghiệm thu hút đông đảo thí sinh theo học năm 2021
Cập nhật thời gian tuyển sinh Cao đẳng Xét nghiệm TPHCM năm 2021
Theo quy chế tuyển sinh Cao đẳng năm 2021 của Bộ Lao động thương binh và xã hội, Trường Cao đẳng Y Dược Pasteur cơ sở TPHCM thông báo tuyển sinh Cao đẳng Xét nghiệm TPHCM với điều kiện thí sinh đã tốt nghiệp THPT hoặc bằng cấp tương đương. Hiện thời gian tuyển sinh Cao đẳng Xét nghiệm được nhà trường mở rộng làm nhiều đợt tuyển sinh, do đó thí sinh có thể gửi hồ sơ xét tuyển vào bất kỳ thời gian nào trong năm để xét tuyển sớm nhất. Dựa và hồ sơ nhà trường sẽ công bố kết quả trúng tuyển trực tiếp cho thí sinh. Việc mở rộng thời gian tuyển sinh mục đích tạo điều kiện cho tất cả các thí sinh ở vùng sâu vùng xa, hải đảo có thời gian để chuẩn bị tốt về mọi mặt. Không chỉ có hệ Cao đẳng Dược mới có thời gian tuyển sinh được mở rộng mà bất kỳ hình thức đào tạo nào cũng được nhà trường nới rộng thời gian tuyển sinh như Cao đẳng Dược, Cao đẳng Vật lý trị liệu hay Cao đẳng Điều dưỡng. Thời hạn đăng ký xét tuyển cuối cùng là trước ngày 15/12/2021.
Thời gian học Cao đẳng Xét nghiệm TPHCM là bao lâu?
Với hệ Cao đẳng Xét nghiệm chính quy, thí sinh sẽ được tiếp cận với chương trình đào tạo đạt chuẩn theo quy định của Bộ đề ra. Học viên theo học hệ Cao đẳng Xét nghiệm chính quy tại Trường Cao đẳng Y Dược Pasteur là 3 năm. Đây là khoá học với thời gian tương đối ngắn mà vẫn đảm bảo đủ khối lượng kiến thức cần thiết, điều này giúp học viên tiết kiệm tối đa thời gian cũng như chi phí học tập. Hoàn thành khoá học, học viên được cấp bằng Xét nghiệm Cao đẳng chính quy và đã có đủ điều kiện xin ứng tuyển vào làm tại các vị trí công tác trong ngành Y tế nước nhà.

Cập nhật thời gian tuyển sinh Cao đẳng Xét nghiệm TPHCM năm 2021
Ngoài đào tạo hệ Cao đẳng Xét nghiệm, trong năm 2021 nhà trường còn đào tạo một vài chuyên ngành mũi nhọn khác trong hệ thống ngành Y Dược như: Cao đẳng Dược, Cao đẳng Hộ sinh, Cao đẳng Vật lý trị liệu và Cao đẳng Điều dưỡng với 3 hệ đào tạo Chính quy, Liên thông và Văn bằng 2. Đây là những ngành nghề được đánh giá là có nhu cầu tuyển dụng lớn trong hệ thống ngành Y tế trong tương lai. Trong quá trình học ở tất cả các hệ đào tạo nhà trường luôn chú trọng đi sâu vào những kiến thức chuyên ngành khi trực tiếp cho sinh viên Cao đẳng Y dược thực hành trong phòng thí nghiệm có đầy trang thiết bị hiện đại và quan sát trực tiếp tại bệnh viện riêng của nhà trường. Mục đích giúp sinh viên có thể nắm bắt được chắc được kiến thức chuyên ngành Xét nghiệm, cũng như hiểu rõ về tính chất công việc của người Kỹ thuật viên Xét nghiệm.
Hồ sơ tuyển sinh Cao đẳng Xét nghiệm TPHCM năm 2021
Nếu yêu thích ngành Xét nghiệm và mong muốn có cơ hội được học tập trong ngôi trường luôn được đánh giá cao bởi chất lượng đào tạo. Thí sinh có thể làm hồ sơ tuyển sinh Cao đẳng Xét nghiệm TPHCM năm 2021 theo sự hướng dẫn sau:
Hồ sơ tuyển sinh Cao đẳng Xét nghiệm TPHCM năm 2021
- 01 phiếu đăng ký xét tuyển Cao đẳng Y dược năm 2021
- 02 Bản pho to có dấu công chứng bằng tốt nghiệp THPT nếu thí sinh đã tốt nghiệp từ những năm trước.
- 02 Giấy chứng nhận tốt nghiệp tạm thời nếu thí sinh vừa thi THPT quốc gia và tốt nghiệp năm 2021.
- 02 Học bạ THPT bản pho to có công chứng.
- 01 Giấy khám sức khỏe cá nhân.
- 01 chứng minh thư nhân dân phô tô công chứng
- 01 phong bì có dán sẵn tem ghi rõ họ tên, địa chỉ, số điện thoại của thí sinh (hoặc người nhà) vào phần người nhận để trường gửi giấy báo nhập học.
- Các loại giấy tờ chứng minh đối tượng ưu tiên khác (nếu thí sinh thuộc diện đối tượng chính sách được hưởng ưu tiên).
Sau khi hoàn thiện hồ sơ xét tuyển Cao đẳng Xét nghiệm TPHCM năm 20201 thí sinh có thể gửi về địa chỉ của nhà trường và đợi kết quả thông báo trúng tuyển từ ban tuyển sinh.
